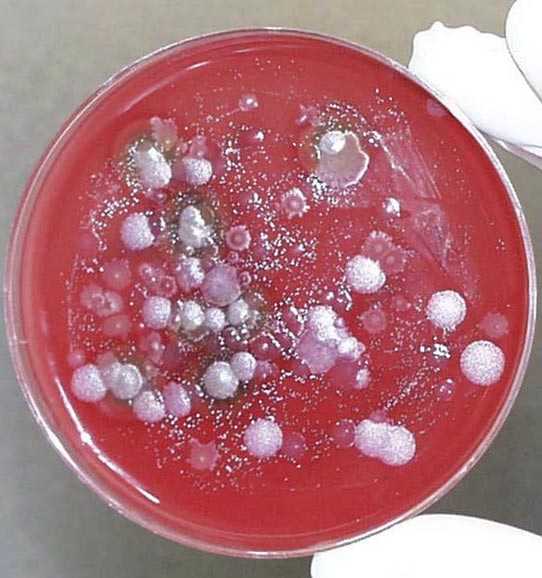

Холера – возбудитель, симптомы, профилактика и диагностика :: SYL.ru
В статье речь пойдет о холере, возбудитель которой довольно стоек в окружающей среде. Это болезнь, известная человечеству достаточно давно. Причины ее появления были выявлены лишь недавно, чего не скажешь о существовании самого возбудителя. Чума, сибирская язва и холера относятся к особо опасным заболеваниям, которые отличаются высокой контагиозностью, тяжелым течением и высокой смертностью. Сегодня именно они являются основой для создания биологического оружия. И хотя современная статистика не дает оснований для беспокойства, минимальные знания об опасных болезнях и их возбудителях могут быть полезны.
Исторический очерк
Человечество на разных периодах своего существования переносило пандемии холеры. Об этом заболевании писал еще Гиппократ (460 год до нашей эры). Именно ему мы обязаны названием болезни – от древнегреческого слова «холе», что означает желчь. Врачи Александра Македонского (365-323 гг. до н. э.) описывали эту болезнь как бедствие, настигнувшее войска в его походе в Индию. Есть теория, что именно холера заставила великого полководца отказаться от своих планов и повернуть назад. До начала 19-го века болезнь была распространена в южной части Азии и Индии. С 1817 по 1975 год мир перенес семь пандемий холеры, которые унесли жизней больше, чем вспышки любой другой болезни.

Именно с середины 19-го века начались масштабные исследования по определению возбудителя холеры. В Европу инфекция прорвалась с войнами и по торговым путям из Азии и Египта. Именно в Египет отправилась в 1881 году исследовательская экспедиция, в которую входил известный бактериолог Роберт Кох (1843-1910). Именно им были открыты возбудители холеры и туберкулеза (вибрионы и палочки Коха). Робертом Кохом были разработаны и первые профилактические рекомендации в отношении данного заболевания.
В соответствии с перечнем Всемирной организации здравоохранения, бактерии-возбудители чумы и холеры, а также сибирской язвы, отнесены к патогенам, вызывающим особо опасные заболевания.
Пандемии холеры
Первая пандемия началась в 1816-м в республике Бангладеш. Тысячи британских военных, миллионы индийцев и сто тысяч жителей острова Ява стали жертвами холеры. В России в 19-м веке холера отметилась «холерными бунтами». Затем она начала свое шествие во Франции, Германии, Великобритании, в каждой стране оставив после себя до 60 тысяч трупов. Попав в США и Канаду, она убила около 250 тысяч жителей.
Последняя пандемия была объявлена в 1962 году. Именно тогда на сцене появился вибрион Эль-Тор. К 1970 году пандемия охватила 39 стран. Она унесла жизни более 40 тысяч человек.
Мировая эпидемиологическая ситуация оставляет определенную настороженность. Так, эпидемия холеры в Японии в июне 1977 года распространилась уже к августу на Ближнем Востоке. Она стала самой большой эпидемией в данном регионе за предыдущие 20 лет. За один месяц холера охватила Сирию, Иорданию, Иран и еще 10 ближневосточных государств.

Рыцари борьбы с холерой
Как уже говорилось, Роберт Кох в 1883 году подробно описал холерный вибрион и симптомы болезни. В том же году будущий лауреат Нобелевской премии по исследованию иммунитета Илья Ильич Мечников (1845-1916) добровольно принял культуру холерного вибриона, чтобы на собственном опыте изучить течение болезни. Удивительно, но он не только выздоровел, но и после болезни у него улучшилось зрение и характер.
Однако звание первооткрывателя вакцины от холеры принадлежит бактериологу Николаю Федоровичу Гамалею (1859-1949), который работал в Одесском центре борьбы с бешенством. Свою вакцину он опробовал на себе и своей супруге. Его исследования продолжил ученик Владимир Аронович Хавкин (1860-1930), также проводивший апробацию своей вакцины на себе. Именно их вакцины оказались наиболее удачными «антихолерными противоядиями».
Бактерии или вирусы?
Возбудителями холеры являются холерные вибрионы (Vibrio cholerae) – грамотрицательные анаэробные бактерии. Вибрион имеет форму изогнутой палочки и снабжен жгутиком. Возбудитель холеры, микробиология которого изучена довольно хорошо, обладает геномом из двух хромосом и размножается в планктоне пресных и соленых водоемов. Известно более 150 серотипов холерного вибриона. Каждый серотип возбудителя холеры относится к условно-патогенным организмам и отличается по соматическому антигену. В зависимости от серотипа и пути попадания инфекции в организм, отличается и течение ее болезни. Но только два серотипа вызывают симптомы недуга.
«Классическая» холера вызывается вибрионом серогруппы О1, в которой выделяют два биотипа – классический (Vibrio cholerae biovar cholerae) и Эль-Тор (Vibrio cholerae biovar eltor). В 1993 году в Юго-Восточной Азии вспышка холеры была вызвана ранее неизвестным вибрионом, который назван Бенгал (серотип 0139). Эти данные говорят о возможной мутации вибриона холеры. Остальные серотипы холерного вибриона не вызывают заболевания у человека. Они часто обнаруживаются в открытых водоемах и называются холероподобными или псевдохолерными. Некоторые являются возбудителями болезней животных и единичных холероподобных заболеваний человека.
Бактерия-возбудитель холеры устойчива при температурах от 16 до 40 градусов, не гибнет при заморозке. Долгое время вибрион проявляет жизнестойкость в водоемах, личных вещах и фекалиях больного. Погибают вибрионы при кипячении, под действием дезинфицирующих средств, содержащих хлор.
Как вибрионы попадают в организм
Возбудители заболевания холеры попадают в желудок орально-фекальным или контакно-бытовым путем. Заразиться можно через воду или пищу. Источником возбудителя холеры может быть свежая или малосольная рыба, мясо, молочные продукты, кондитерские изделия, овощи и фрукты, промытые зараженной водой. Инфицирование возможно через грязные руки, посуду или личные вещи больного. Источником возбудителя холеры всегда является больной. Воздушно-капельным путем инфекция не передается. Самый опасный период для заражения – контакт с больным в первые дни заболевания, к 3-й неделе контагиозность больного падает. Зарегистрированы случаи, когда человек был носителем вибриона в течении года. Наиболее распространенный сегодня возбудитель холеры – вибрион Эль-Тор, характеризующийся течением болезни в стертой форме и носительством заболевания.
Что происходит в организме
Бактерии-возбудители холеры являются тропными к тонкому кишечнику человека. Проникнув в организм, холерные вибрионы активно размножаются в тонком кишечнике, повреждают его слизистые оболочки и вырабатывают огромное количество токсинов. Именно токсины (экзотоксины и эндотоксины) вибрионов-возбудителей холеры вызывают нарушения водно-солевого баланса, обезвоживание, нарушение работы нервной системы. Все эти воздействия приводят к судорогам и смерти больного в результате дегидрационного шока. Токсины возбудителя холеры через поврежденные слизистые кишечника быстро попадают в кровоток и вызывают острую интоксикацию и ослабление организма, что повышает риск присоединения вторичных инфекций.
Диагностика холеры
Методы простой микроскопии способны установить наличие возбудителя холеры уже в первые часы заражения. Как это делается?
Классическим методом для определения возбудителя холеры является методика посева на питательные среды. Для анализа берут рвотные массы или фекалии больного. Анализ готов в течении 36-48 часов.
Ускоренные методики не являются достаточно достоверными, а служат лишь подтверждением основной диагностики.

Симптоматика и клиническая картина
Инкубационный период болезни составляет от нескольких часов до 6 дней с момента попадания возбудителя холеры в организм. Начало болезни всегда острое и сопровождается следующими симптомами:
- Частый (до 15 раз в сутки) и жидкий стул. Особенность – это отсутствие зловонного запаха и урчание в животе.
- Тошнота и рвота.
- Острые боли в брюшной полости.
- Повышение температуры до 40 градусов, а затем ее постепенное уменьшение до ощущения постоянного озноба.
- Обезвоживание и чувство жажды.
- Головокружения, слабость.
Развитие болезни не влияет на сознание. Через несколько часов появляется цианоз губ и бледность кожных покровов. Обезвоживание приводит к обострению черт лица, темным кругам под глазами, хриплому голосу. Тургор кожи снижается, кожа на кистях рук сморщивается («руки прачки»). Нарушается ритм сердечных сокращений, артериальное давление повышается, появляются проблемы с дыханием, нарастает почечная недостаточность.
Лечение болезни
При первых симптомах необходимо срочное оказание медицинской помощи. Больной госпитализируется в инфекционное отделение в отдельный бокс. Лечение направлено на устранение патогена и восстановление водно-солевого баланса в организме. Кроме антибактериальной терапии, назначаются препараты для нормализации работы пищеварительного тракта и восстановление слизистых кишечника. В острой форме предписана строгая диета, в которой преобладают продукты с большим содержанием солей калия. Общий курс лечения длится до 14 дней.

Прогноз может быть положительным только при своевременном стационарном лечении. После выздоровления формируется иммунитет, но только к данному серотипу холеры. Инфицирование другими серотипами вполне возможно.
Профилактика заболевания
Профилактические санитарно-гигиенические мероприятия состоят из государственных и индивидуальных, а также включают в себя вакцинацию.
Среди мероприятий можно выделить следующие:
- Предупреждения занесения холерного вибриона из очагов инфекции.
- Раннее выявление и своевременная изоляция больных.
- Меры по обеззараживанию водоемов общего пользования.
- Обеззараживание питьевой воды.
- Личная гигиена и термическая обработка пищи.
- Применение пероральных вакцин.

Противохолерные вакцины
Первые вакцины появились в 1800-х годах, а пероральные вакцины в 1990-х годах. Вакцина против холеры является базовой в системе здравоохранения и входит в перечень основных лекарственных средств Всемирной организации здравоохранения. Сегодня существует три сертифицированных более чем в 60 странах пероральных вакцины – обычная и модифицированная WC/rBS, и CVD 103-HgR. Все они безопасны, побочными эффектами могут быть понос и умеренные боли в животе. В 85 % их защитное действие длится полгода, в 60 % — до года. Рекомендуется проведение вакцинации лицам с повышенным риском заражения, но они безопасны и эффективны для беременных и лиц с низким иммунным статусом.

Современная ситуация
Статистика Всемирной организации здравоохранения говорит о том, что в мире ежегодно заболевает холерой до 5 миллионов человек, из которых 100 тысяч умирает. Заболевание холерой коррелирует с уровнем жизни и распространено в пятидесяти странах мира. Чем ниже социально-экономический уровень жизни, тем выше риск встретиться с возбудителями холеры и чумы. Высокозаразный холерный вибрион и сегодня активен в Африке, Азии и Индии. Только в 2010 году во время эпидемии холеры в Эфиопии умерло около 8 тысяч человек.
А что у нас?
По данным исследовательского противочумного института «Микроб», россияне вполне могут столкнуться, кроме стандартных вирусов, с возбудителями холеры, чумы и сибирской язвы.
Вспышка чумы вполне возможна на Алтае. В 2016 году тут заболел десятилетний мальчик, который вместе с семьей разделывал тушки сурков.
Разрушительный ураган «Мэтью», пролетевший над Гаити в 2016 году, вымыл холерный эмбрион, и в некоторые дни после урагана регистрировалось до 250 случаев холеры на островах. В 2014 году в Россию инфекцию привезли туристы из Индии. Сколько туристов было на Гаити в прошлом году, и кто мог там заразиться, пока не известно.
А вот на Ямале в 2016 году у 36 человек диагностировали сибирскую язву. Переносчиками стали невакцинированные северные олени.

И вновь продолжается бой
Несмотря на то что в арсенале современной медицины есть эффективные вакцины, действенные антибиотики и сильные средства дегидратации, холера продолжает удивлять своими вспышками. 53 страны мира регулярно посылают отчеты во Всемирную организацию здравоохранения в соответствии с положением о международном надзоре за особо опасными инфекциями. Дает эти отчеты и Российская Федерация.
Пусть на фоне обнаруженных штаммов подозрительных патогенных микроорганизмов мы пока не столкнулись со случаями массового инфицирования, о способностях бактерий к мутациям забывать не стоит. Как и о том, что холера была и остается «болезнью грязных рук».
www.syl.ru
причины, симптомы, диагностика и лечение
Холера – это острая кишечная инфекция, возникающая при поражении человека холерным вибрионом. Холера проявляется выраженной частой диареей, обильной многократной рвотой, что приводит к значительной потере жидкости и обезвоживанию организма. Признаками дегидратации служат сухость кожных покровов и слизистых, снижением тургора тканей и сморщивание кожи, заострение черт лица, олигоанурия. Диагноз холеры подтверждается результатами бактериологического посева каловых и рвотных масс, серологическими методиками. Лечение включает изоляцию холерного больного, парентеральную регидратацию, терапию тетрациклиновыми антибиотиками.
Общие сведения
Холера – особо опасная инфекция, вызываемая энтеропатогенной бактерией Vibrio cholerae, протекающая с развитием тяжелого гастроэнтерита и выраженным обезвоживанием вплоть до развития дигидратационного шока. Холера имеет тенденцию к эпидемическому распространению и высокую летальность, поэтому отнесена ВОЗ к высокопатогенным карантинным инфекциям. Наиболее часто эпидемические вспышки холеры регистрируются в странах Африки, Латинской Америки, Юго-Восточной Азии. По оценкам ВОЗ, ежегодно холерой заражается 3-5 млн. человек, около 100-120 тыс. случаев заболевания заканчивается смертельно. Т. о., на сегодняшний день холера остается глобальной проблемой мирового здравоохранения.
Холера
Характеристика возбудителя
На сегодняшний день обнаружено более 150 типов холерных вибрионов, различающихся по серологическим признакам. Холерные вибрионы разделяют на две группы: А и В. Холеру вызывают вибрионы группы А. Холерный вибрион представляет собой грамотрицательную подвижную бактерию, выделяющую в процессе жизнедеятельности термостабильный эндотоксин, а также термолабильный энтеротоксин (холероген).
Возбудитель устойчив к действию окружающей среды, сохраняет жизнеспособность в проточном водоеме до нескольких месяцев, до 30 часов в сточных водах. Хорошей питательной средой является молоко, мясо. Холерный вибрион погибает при химическом дезинфицировании, кипячении, высушивании и воздействии солнечного света. Отмечается чувствительность к тетрациклинам и фторхинолонам.
Резервуаром и источником инфекции является больной человек или транзиторный носитель инфекции. Наиболее активно выделяются бактерии в первые дни с рвотными и фекальными массами. Тяжело выявить инфицированных лиц с легко протекающей холерой, однако они представляют опасность в плане заражения. В очаге обнаружения холеры обследованию подвергаются все контактировавшие, вне зависимости от клинических проявлений. Заразность с течением времени уменьшается, и обычно к 3-й неделе происходит выздоровление и освобождение от бактерий. Однако в некоторых случаях носительство продолжается до года и более. Удлинению срока носительства способствуют сопутствующие инфекции.
Холера передается бытовым (грязные руки, предметы, посуда), пищевым и водным путем по фекально-оральному механизму. В настоящее время особое место в передаче холеры отводится мухам. Водный путь (загрязненный источник воды) является наиболее распространенным. Холера является инфекцией с высокой восприимчивостью, наиболее легко происходит заражение людей с гипоацидозом, некоторыми анемиями, зараженных гельминтами, злоупотребляющих алкоголем.
Симптомы холеры
Инкубационный период при заражении холерным вибрионом продолжается от нескольких часов до 5 дней. Начало заболевания острое, обычно ночью или утром. Первым симптомом выступает интенсивный безболезненный позыв к дефекации, сопровождающийся дискомфортным ощущением в животе. Первоначально стул имеет разжиженную консистенцию, но сохраняет каловый характер. Довольно быстро частота дефекаций увеличивается, достигает 10 и более раз за сутки, при этом стул становится бесцветным, водянистым. При холере испражнения обычно не зловонны в отличие от других инфекционных заболеваний кишечника. Повышенная секреция воды в просвет кишечника способствует заметному увеличению количества выделяемых каловых масс. В 20-40% случаев кал приобретает консистенцию рисового отвара. Обычно испражнения имеют вид зеленоватой жидкости с белыми рыхлыми хлопьями, похожими на рисовые.
Нередко отмечается урчание, бурление в животе, дискомфорт, переливание жидкости в кишечнике. Прогрессирующая потеря жидкости организмом приводит к проявлению симптомов обезвоживания: сухость во рту, жажда, затем появляется ощущение похолодания конечностей, звон в ушах, головокружение. Эти симптомы говорят о значительном обезвоживании и требуют экстренных мер по восстановлению водно-солевого гомеостаза организма.
Поскольку к диарее зачастую присоединяется частая рвота, потеря жидкости усугубляется. Рвота возникает обычно спустя несколько часов, иногда на следующие сутки после начала диареи. Рвота обильная, многократная, начинается внезапно и сопровождается интенсивным ощущением тошноты и болью в верхней части живота под грудиной. Первоначально в рвотных массах отмечаются остатки непереваренной пищи, затем желчь. Со временем, рвотные массы также становятся водянистыми, приобретая иногда вид рисового отвара.
При рвоте происходит быстрая потеря организмом ионов натрия и хлора, что приводит к развитию мышечных судорог, сначала в мышцах пальцев, затем всех конечностей. При прогрессировании дефицита электролитов мышечные судороги могут распространиться на спину, диафрагму, брюшную стенку. Мышечная слабость и головокружение нарастает вплоть до невозможности подняться и дойти до туалета. При этом сознание полностью сохраняется.
Выраженной болезненности в животе, в отличие от большинства кишечных инфекций, при холере не отмечается. 20-30% больных жалуются на умеренную боль. Не характерна и лихорадка, температура тела остается в нормальных пределах, иногда достигает субфебрильных цифр. Выраженная дегидратация проявляется снижением температуры тела.
Сильное обезвоживание характеризуется побледнением и сухостью кожных покровов, снижением тургора, цианозом губ и дистальных фаланг пальцев. Сухость характерна и для слизистых оболочек. С прогрессированием дегидратации отмечают осиплость голоса (снижается эластичность голосовых связок) вплоть до афонии. Черты лица заостряются, живот втягивается, под глазами проявляются темные круги, сморщивается кожа на подушечках пальцев и ладонях (симптом «рук прачки»). При физикальном исследовании отмечается тахикардия, артериальная гипотензия. Снижается количество мочи.
При дальнейшей потере жидкости (потеря более 10% массы тела) и ионов происходит прогрессирование дегидратации. Возникает анурия, значительная гипотермия, пульс в лучевой артерии не прощупывается, периферическое артериальное давление не определяется. При этом диарея и рвота становятся менее частыми в связи с параличом кишечной мускулатуры. Данное состояние называют дегидратационным шоком.
Дегидратация организма различается по стадиям: на первой стадии потеря жидкости не превышает 3% от массы тела, вторая и третья стадии подразумевает потерю в размере 3-6 и 6-9% массы тела соответственно, и на четвертой стадии (дигидратационный шок) потеря жидкости превышает 9% массы тела. Нарастание клинических проявлений холеры может прекратиться на любом этапе, течение может быть стертым. В зависимости от тяжести дегидратации и скорости нарастания потери жидкости различают холеру легкого, среднетяжелого и тяжелого течения. Тяжелая форма холеры отмечается у 10-12% пациентов. В случаях молниеносного течения развитие дегидратационного шока возможно в течение первых 10-12 часов.
Холера может осложняться присоединением других инфекций, развитием пневмонии, тромбофлебита и гнойного воспаления (абсцесс, флегмона), тромбозом сосудов брыжейки и ишемией кишечника. Значительная потеря жидкости может способствовать возникновению расстройств мозгового кровообращения, инфарктом миокарда.
Диагностика холеры
Тяжело протекающая холера диагностируется на основании данных клинической картины и физикального обследования. Окончательный диагноз устанавливают на основании бактериологического посева каловых или рвотных масс, кишечного содержимого (секционный анализ). Материал для посева необходимо доставить в лабораторию не позднее 3-х часов с момента получения, результат будет готов через 3-4 суток.
Существуют серологические методики выявления заражения холерным вибрионом (РА, РНГА, виброцидный тест, ИФА, РКА), но они не являются достаточными для окончательной диагностики, считаясь методами ускоренного ориентировочного определения возбудителя. Ускоренными методиками для подтверждения предварительного диагноза можно считать люминисцентно-серологический анализ, микроскопию в темном поле иммобилизованных О-сывороткой вибрионов.
Лечение холеры
Поскольку основную опасность при холере представляет прогрессирующая потеря жидкости, ее восполнение в организме является основной задачей лечения этой инфекции. Лечение холеры производится в специализированном инфекционном отделении с изолированной палате (боксе), оборудованной специальной койкой (койка Филипса) с весами и посудой для сбора испражнений. Для точного определения степени дегидратации ведут учет их объема, регулярно определяют гематокрит, уровень ионов в сыворотке, кислотно-щелочной показатель.
Первичные регидратационные мероприятия включают восполнение имеющегося дефицита жидкости и электролитов. В тяжелых случаях производится внутривенное введение полиионных растворов. После этого производят компенсаторную регидратацию. Введение жидкости происходит в соответствии с ее потерями. Возникновение рвоты не является противопоказанием к продолжению регидратации. После восстановления водно-солевого баланса и прекращения рвоты начинают антибиотикотерапию. При холере назначают курс препаратов тетрациклинового ряда, а в случае повторного выделения бактерий – хлорамфеникол.
Специфической диеты при холере нет, в первые дни могут рекомендовать стол №4, а после стихания выраженной симптоматики и восстановления кишечной деятельности (3-5-й лень лечения) — питание без особенностей. Перенесшим холеру рекомендовано увеличить в рационе содержащие калия продукты (курага, томатный и апельсиновый соки, бананы).
Прогноз и профилактика холеры
При своевременном и полном лечении после подавления инфекции наступает выздоровление. В настоящее время современные препараты эффективно действуют на холерный вибрион, а регидратационная терапия способствует профилактике осложнений.
Специфическая профилактика холеры заключается в однократной вакцинации холерным токсином перед посещением регионов с высоким уровнем распространения этого заболевания. При необходимости через 3 месяца производят ревакцинацию. Неспецифические меры профилактики холеры подразумевают соблюдение санитарно-гигиенических норм в населенных местах, на предприятиях питания, в районах забора вод для нужд населения. Индивидуальная профилактика заключается в соблюдении гигиены, кипячении употребляемой воды, мытье продуктов питания и их правильной кулинарной обработке. При обнаружении случая холеры эпидемиологический очаг подлежит дезинфекции, больные изолируются, все контактные лица наблюдаются в течение 5-ти дней на предмет выявления возможного заражения.
www.krasotaimedicina.ru
Возбудитель холеры – чем опасный? Причины, методы лечения холеры
На чтение 7 мин. Опубликовано
Холера – одно из опасных кишечных заболеваний, которое относится к карантинным инфекциям. Еще несколько десятков лет назад холера регистрировалась во многих странах мира, унося жизни тысяч людей. Холеру можно сравнить с такими заболеваниями, как чума, сибирская язва, туляремия и другими тяжелыми инфекциями.
Возбудитель инфекции – холерный вибрион. Встречается в открытых водоемах, сточных водах, может развиваться в молоке и мясных продуктах.В наши дни холера не настолько опасна как раньше, и встречается крайне редко. Последние вспышки холеры были зафиксированы в 1993 году в странах Азии и одиночные случаи в Казахстане, Украине и России. Снижение частоты заболеваемости среди населения в разных странах мира произошло благодаря международным санитарным соглашениям, которые регламентируют ряд санитарно-профилактических мероприятий по организации строгого контроля карантинных инфекций.
Этиология
Возбудитель холеры – бактерия холерный вибрион, которая имеет форму изогнутой палочки. Бактерия достаточно подвижна и обитает в основном в тонком кишечнике. Существует более 140 серотипов бактерии данной группы, но только два типа вызывают симптомы холеры: Vibrio cholerae и Vibrio eltor. После проникновения в организм человека бактерии начинают активно размножатся, вырабатывают большое количество токсинов, которые изначально повреждают слизистую оболочку тонкого кишечника, нарушают электролитный баланс, приводят к обезвоживанию организма.
Токсины, которые вырабатывает холерный вибрион, разрушают слизистую тонкой кишки, всасывание солей натрия, что, в свою очередь, приводит к нарушению водно-солевого баланса, работы нервной системы, судорогам и смерти человека.
Возбудитель холеры сохраняет свою жизнедеятельность при температуре 16–40 градусов. Устойчив к низким температурам и не гибнет при замораживании. В основном причиной холеры является один из типов холерного вибриона: группа А (эндоксин) или В (холероген). Оба типа болезни имеют сходную морфологию и продуцируют два токсины эндоксин и экзотоксин (холероген), которые и являются опасными для организма человека и вызывают характерную симптоматику.
Особенностью возбудителя холеры является их быстрый рост в желудочной среде. Свою жизнедеятельность бактерия может сохранять длительное время в водоемах, продуктах питания, а также фекалиях и личных вещах больного человека. Погибает холерный вибрион при кипячении, а также под воздействием мощных дезинфицирующих препаратов и средств, содержащих хлор. Именно поэтому в качестве профилактики болезни рекомендуется использовать хлорсодержащие вещества.
Холера – тяжелое инфекционное заболевание, повреждающее слизистую оболочку тонкого кишечника.Чем опасны токсины возбудителя холеры?
Энтеротоксин холероген, который выделяют бактерии после проникновения в слизистую тонкого кишечника, приводят к резкому увеличению секреции электролитов и воды, которые выводятся вместе с обильной рвотой и многократным жидким стулом. Это вызывает уменьшение объема циркулирующей крови, отмечается сгущение крови, потеря калия, что вызывает метаболический ацидоз. Потеря жидкости при холере в первые сутки и дни болезни может превышать массу тела больного. Такие нарушения ведут к судорогам конечностей, дегидратационному шоку, что и является причиной смерти больного.
Токсины, которые в процессе своей жизнедеятельности выделяет возбудитель холеры, разрушают слизистую желудка, быстро проникают в кровяной поток, после чего возникает сильнейшая интоксикация организма с последующим нарушением работы нервной и сердечно-сосудистой систем. При холере повышается риск присоединения и другой инфекции, что еще больше усугубляет процесс лечение и состояние больного.
Возбудитель холеры разрушает слизистую желудка.Источники заражения
Возбудители холеры проникают в слизистую желудка через рот, после чего прикрепляются к стенке тонкого кишечника, где и начинают свое активное размножение, выделяя токсические вещества. Заразиться холерой можно через воду, пищу или контактно-бытовым путем. Чаще всего инфицирование происходит через воду в открытых водоемах, свежую или малосольную рыбу. Источник болезни также может присутствовать в молочных продуктах, кондитерских изделиях, мясе, овощах и фруктах.
Передается холера через грязные руки, посуду или личные вещи больного человека. Распространенным способом передачи инфекции считается фекально-оральный путь, который заключается в выделении бактерий в окружающую среду при рвоте или обильном стуле. Воздушно-капельным путем инфекция холеры не передается.
Возбудитель холеры попадает в организм человека через воду и пищу.Группа риска
Холера относится к инфекциям высокой восприимчивости. Огромное значение в ее развитии имеет состояние иммунной системы человека. В группе риска находятся дети, а также лица, в анамнезе которых присутствует гипоацидоз, анемия, паразитарные заболевания, патологии желудочно-кишечного тракта воспалительного характера.
Если у человека диагностирована холера, важна полная его изоляция, которая позволит предотвратить заражение других людей. В помещениях, где был больной, проводится дезинфекция, а все люди, которые контактировали с ним, должны пройти ряд исследований на определение бактерии холеры.
Человека с признаками холеры необходимо полностью изолировать.Как проявляется холера?
Инкубационный период при холере составляет 2–6 дней после контакта с источником инфекции или инфицированным человеком. Начало – острое, у человека появляются следующие симптомы:
- обильный жидкий стул, больше 15 раз в день;
- тошнота, многократная рвота;
- схваткообразные и острые боли в желудке;
- повышение температуры тела до 40 градусов;
- повышенное чувство жажды;
- головокружение;
- упадок сил.
Через несколько часов после проявления первых симптомов болезни происходит сильное обезвоживание организма, отмечаются бледность и сухость кожных покровов, цианоз губ. Черты лица заостряются, появляется охриплость голоса, под глазами присутствуют темные круги, отмечается нарушение ритма сердца, повышается артериальное давление, снижается количество мочи. При таком тяжелом состоянии больного несвоевременно оказанная помощь может привести к смерти человека.
На фоне сильного обезвоживания организма повышается риск развития почечной недостаточности, возникают проблемы с дыханием и работой сердечно-сосудистой системой. Именно поэтому при первых признаках болезни необходимо как можно быстрее обратиться к врачам. Чем раньше будет диагностирован источник инфекции, проведены медицинские манипуляции, тем больше шансов на выздоровление.
После первых симптомов заражения можно наблюдать обезвоживание организма, повышение температуры тела, упадок сил.Методы лечения
При холере больного следует срочно госпитализировать в инфекционное отделение. Чтобы избежать инфицирования других людей, больного помещают в отдельную палату.
Важным в лечении холеры считается подавление болезнетворной бактерии и выведение ее из организма, а также восстановление водно-солевого баланса. В условиях стационара больному внутривенно вводят растворы хлорид калия и натрия, а также бикарбонат натрия и глюкозу.
Важная роль в лечении отводится антибактериальной терапии. Больному могут назначаться одновременно несколько антибактериальных препаратов широкого спектра действия. Медикаментозное лечение также включает прием препаратов, которые нормализуют работу пищеварительной системы: ферменты, пробиотики, нитрофураны. Они восстанавливают слизистую желудка, борются с источником инфекции, оказывают мощное противомикробное воздействие.
В острый период назначается строгая диета, которая включает употребление продуктов, богатых солями калия. Больному запрещается употреблять жирные, острые и жареные блюда, также нужно отказаться от алкоголя.
Лечение холеры в условиях стационара очень важно, поскольку в домашних условиях на положительный результат не стоит надеяться. Весь курс лечения может занять до 14 дней. Выписка пациента из стационара проводиться только после сдачи бактериологического исследования на бактерию холеры.
Прогноз на выздоровление положительный только в том случае, когда лечение проводится при первых проявлениях инфекции.
Профилактика
В регионах с повышенной частотой заболеваемости холерой проводится специфическая профилактика, которая состоит из вакцинации холерным токсином. Помимо вакцинации, профилактика холеры заключается в соблюдении правил личной гигиены, правильной обработке пищи, употреблении только кипяченой воды. Такие профилактические меры не смогут на 100% защитить от инфекции, но позволят значительно снизить шансы на заражение холерой.
proinfekcii.ru
Холера – возбудитель, симптомы, лечение, профилактика
Холера – острое инфекционное заболевание, вызываемое холерными вибрионами, характеризующееся фекально-оральным механизмом передачи и протекающее с развитием деминерализации и дегидратации различной степени тяжести.
В этой статье речь пойдет о путях заражения и возбудителе холеры, симптомах заболевания, а также о современных методах диагностики холеры. Также в статье рассказывается о мероприятиях по профилактике холеры и способах лечения данной болезни.
Природа возникновения заболевания
Заболевание относится к числу карантинных инфекций ввиду способности к пандемическому распространению. В развитых странах встречается крайне редко, но возбудитель холеры довольно часто встречается в странах Африки, Южной и Юго-восточной Азии, Южной Америки.
Возбудитель холеры – холерный вибрион Vibrio cholerae, устойчивый к низким температурам и сохраняющий жизнеспособность в открытых водоемах на протяжении нескольких месяцев. Во внешней среде и на пищевых продуктах возбудитель холеры выживает в течение 3-5 дней, а воздействие прямых солнечных лучей сокращает его жизненный цикл до 8-10 часов. Холерный вибрион погибает при кипячении и под воздействием различных средств дезинфекции, высокочувствителен к высушиванию, хлорсодержащим препаратам и кислой среде. Поэтому различные дезинфицирующие средства или кипячение нередко используются как меры профилактики холеры.
Источник возбудителя холеры – это всегда больной человек или бациллоноситель (человек, побывавший в неблагоприятном по холере регионе). Заражение происходит фекально-оральным путем. В неблагоприятных регионах большинство эпидемий напрямую связано с употреблением загрязненной бактериями воды. В быту возбудитель холеры нередко напрямую попадает в воду и на пищу с инфицированными рвотными массами и калом, которые при холере не имеют окраски и специфического запаха, не вызывают брезгливости у окружающих, чем и создают иллюзию безопасности. Поэтому, хотя и случаи передачи заболевания от человека к человеку крайне редки, каждому, кто находился в контакте с больным, в целях профилактики холеры следует придерживаться строгих правил личной гигиены.
Различают пищевые, водные, контактно-бытовые и смешанные эпидемии холеры. Восприимчивость человека к возбудителю холеры очень высока, но современные методы диагностики холеры позволяют выявить заболевание достаточно быстро и предотвратить развитие эпидемии.
Симптомы холеры
Инкубационный период болезни чаще всего составляет 2-3 дня, но в общем он может длиться от нескольких часов до 5-6 дней. Следует отметить, что в ряде случаев у больного вообще не наблюдается каких-либо симптомов холеры, но при этом до 90% пациентов все же ощущают дискомфорт различной степени тяжести.
Основной симптом холеры – жидкий стул, начинающийся, как правило, внезапно. Затем к диарее присоединяется рвота. На начальной стадии заболевания боль в животе и судороги могут отсутствовать, но затем и они присоединяются к симптомам заболевания. Быстрой потерей жидкости объясняются такие симптомы холеры, как острое чувство жажды, головокружение и усталость.
Степени тяжести заболевания
Когда потеря жидкости достигает критического значения, симптомы холеры в виде поражения ЖКТ отходят на второй план, уступая место нарушению деятельности основных систем организма. Тяжесть этих нарушений определяется степенью дегидратации:
- первая степень – неявно выраженная дегидратация;
- вторая степень – масса тела уменьшается на 4-5%, снижается уровень гемоглобина и число эритроцитов, ускоряется СОЭ. Пациенты ощущают головокружение, жажду и сухость во рту. Наблюдается посинение губ и пальцев рук, возможны судороги жевательных и икроножных мышц, появляется осиплость голоса;
- третья степень – потеря массы тела достигает 8-9%. К обострению вышеперечисленных симптомов присоединяется снижение температуры тела и падение артериального давления, возможен коллапс. В крови понижается концентрация хлора и калия, сама кровь значительно сгущается;
- четвертая степень – потеря массы тела превышает 10%. Пациент впадает в состояние прострации, развивается шок. Черты лица заостряются, кожа становится холодной и синюшной, нарастает частота и продолжительность тонических судорог. Отмечается резкое падение артериального давления и приглушенность тонов сердца. Лечение холеры на четвертой степени дегидратации малоэффективно.
Тяжелая форма холеры приходится на одного из двадцати заболевших. Развиваться может стремительно и без правильного лечения и ухода приводит к летальному исходу за считанные часы. Поэтому при первых же симптомах холеры необходимо немедленно обращаться к врачу.
Диагностика холеры
Диагностика холеры производится на основании эпидемиологических, анамнестических, лабораторных и клинических исследований.
Обязательным является лабораторное обследование больных. Современная диагностика холеры объединяет в себе так называемое «классической исследование», растягивающееся на 36 часов, и ускоренные методы, позволяющие выделить холерный эмбрион уже через 2-5 часов с момента начала исследования.
Главный метод диагностики холеры – бактериологический. Такой метод направлен на выделение культуры возбудителей из рвотных и каловых масс. В случае смерти пациента диагностику холеры осуществляют с помощью исследования отрезков тонкой кишки.
Лечение холеры
Госпитализация обязательна для всех заболевших. Ведущая роль в лечении холеры отводится восстановлению водно-солевого баланса организма и борьбе с обезвоживанием. Применяют растворы, содержащие хлорид калия и натрия, бикарбонат натрия и глюкозу. Растворы вводят с помощью капельницы. При тяжелом обезвоживании допустимо струйное введение жидкости, которое проводят до нормализации пульса. Во время лечения холеры в рацион пациента включают продукты богатые солями калия (картофель, томаты, курагу).
Терапия с помощью антибиотиков проводится только больным с тяжелой третьей и четвертой степенью дегидратации. В таких случаях лечение холеры осуществляется с помощью левомицетина или тетрациклина.
Лечение холеры заканчивается выпиской пациента только после подтверждения отрицательных анализов бактериологических исследований. Во многом успех лечения холеры зависит от того, насколько вовремя больной обратился за медицинской помощью.
Профилактика холеры
После того как человек перенес это опасное заболевание, пожизненный иммунитет к болезни у него не вырабатывается. Поэтому важность профилактики холеры сложно переоценить.
Мероприятия по профилактике холеры направлены на осуществление эпидемиологического надзора, предупреждение распространения инфекции на территорию страны людьми, побывавшими в неблагополучных по холере регионах, улучшение санитарно-коммунального состояния населенных пунктов.
Специфической профилактикой холеры считают вакцинацию. Эффективность ее спорна.
dolgojit.net
Холера — возбудитель, лечение, симптомы, профилактика холеры
Холера – это патология инфекционного генеза, протекающая в виде острого кишечного антропонозного заболевания, в развитии которого ключевую роль занимает заражения организма специфическим возбудителем, который относится к виду Vibrio cholerae.
Заражение холерой здорового человека происходит, как правило, фекально-оральным способом и сопровождается развитием поражения исключительно тонкого отдела кишечника, что проявляется в виде водянистой диареи, неукротимой рвоты, молниеносной нарастающей потерей организмом жидкости с электролитами и при отсутствии своевременной медикаментозной коррекции – гиповолемического шока и смерти.
Вибрион холеры чаще всего очень быстро распространяется, тем самым провоцируя развитие заболевания в форме эпидемий. Природные эндемичные по холере очаги находятся в африканских, латиноамериканских, азиатских странах. Источник холеры представляет собой не только больного человека, но и вибрионосителя, который длительное время может выделять возбудителей.
Согласно достоверным показателям мировой статистики случаев инфекционных заболеваний, на долю холеры ежегодно приходится до 43 миллионов эпизодов холеры, из которых 5% заканчивается летальным исходом, что является крайне неблагоприятным показателем. В 80% случаев больной холерой полностью выздоравливает, применяя исключительно пероральные методы регидратации, поэтому данная методика должна обязательно входить в комплекс лечебных мероприятий, как при легком, так и тяжелом течении заболевания.
Заражение холерой можно избежать, если полностью обеспечить население очищенной питьевой водой и средствами санитарии. Дополнительными профилактическими мерами является применение оральных противохолерных вакцин, которые должны использоваться повсеместно.
Эпидемия холеры развивается молниеносно результате короткого инкубационного периода, который характерен для данной инфекционной патологии и составляет в среднем несколько суток.
Возбудитель холеры
Известными в настоящее время возбудителями холеры являются 140 серогрупп Vibrio cholerae, однако, в классическом клиническом варианте холера развивается при попадании в организм человека холерного вибриона О1 серогруппы. Инфекционистами принято разделять данную серогруппу холерного вибриона на Vibrio cholerae biovar cholerae и Vibrio cholerae biovar eltor, которые характеризуются сходными морфологическими, культуральными, а также серологическими характеристиками.
Вибрион холеры представляет собой короткую изогнутую подвижную палочку, которая имеет жгутик. Возбудителями холеры являются грамотрицательные анаэробы, хорошо окрашивающиеся анилиновыми красителями, способными образовывать споры и капсулы, хорошо растут на щелочных средах при условии поддержания температурной реакции 10-40°C.
Эпидемия холеры в Индии в 1992 году была спровоцирована Vibrio cholerae non-01 который вызывает различной интенсивности диарею, отличается высоким показателем летальности.
В роли ворот инфекции при холере выступают верхние отделы пищеварительного тракта. Часть холерных вибрионов, которые попадают в ротовую полость, погибает в полости желудка под влиянием хлористоводородной кислоты. Клиническая картина холеры развивается только в том случае, когда возбудители проникают в просвет тонкого кишечника и сохраняют не только признаки жизнедеятельности, но и способность к активному размножению и выделение экзотоксина. Больной холерой (источник холеры) начинает предъявлять патогномоничные для данной патологии жалобы в случае наличия огромных доз холерного вибриона.
Развитие типичного холерного симптомокомплекса обусловлено наличием у возбудителя холеры способности выделять белковый энтеротоксин и нейраминидазу.
Главной функцией нейраминидазы холерного вибриона является расщепление кислотных остатков ацетилнейраминовой кислоты и образование из ганглиозидов специфических рецепторов, усиливающих действие холерогена. Образованный комплекс, состоящий из холерогена и специфического рецептора, становится активатором аденилатциклазы, увеличивает выработку аденозинмонофосфата. Главной функцией аденозинмонофосфата регуляция секреции воды и электролитов из клеточного содержимого в просвет тонкой кишки. Результатом активации данного механизма являются обильная секреция большого количества изотонической жидкости слизистой оболочки тонкого кишечника, которая не в полном объеме всасывается толстым кишечником. Клинически данные патофизиологические изменения проявляются профузным поносом.
Примечательным фактом является то, что различные формы холеры никогда не провоцируют развитие грубых патоморфологических изменений эпителиоцитов тонкой кишки. Кроме того, гистологическое и лабораторное исследование холеры ни при каких условиях не позволял обнаружить наличие холерного токсина в лимфе и крови. До сих пор инфекционистами и патоморфологами не было получено данных о патологическое влияние холерного токсина на внутренние органы, за исключением тонкого кишечника.
Жидкость, которая активно секретируется в тонком кишечнике, содержит минимальное количество белка и большую концентрацию различных электролитов в виде натрия, калия, бикарбоната и хлоридов. Количество выделяемой жидкости ежечасно составляет не менее 1л. Следствием таких изменений является значительное уменьшение содержания плазмы в циркулирующей крови с параллельным перемещением жидкости из интерстиция во внутрисосудистое пространство. Продолжается потеря жидкости вследствие диареи становится причиной гемодинамических расстройств с сопутствующими микроциркуляторными нарушениями, что провоцирует развитие дегидратационного шока и почечной недостаточности.
В плазме циркулирующей крови содержание бикарбонатов в несколько раз меньше, чем в фекалиях. Кроме того, в фекалиях отмечается чрезмерное накопление калия. Вышеперечисленные электролитные нарушения достаточно эффективно купируются проведением активной инфузионной терапии. При условии применения инфузионной терапии в полном объеме при холере, у пациента быстро развивается и прогрессирует острая почечная недостаточность и сопутствующая гипокалиемия , которая становится причиной развития атонии кишечника, артериальной гипотензии , нарушения ритмичности сердечной деятельности. Вследствие нарушения мочевыделительной функции почек развивается азотемия, негативное воздействие которой проявляется в первую очередь на структуры центральной нервной системы в виде развития различной степени нарушения сознания.
Симптомы и признаки холеры
Холера относится к инфекционным патологиям с коротким инкубационным периодом, продолжительность которого не превышает одних суток. Клинические формы холеры различаются в первую очередь по интенсивности клинической симптоматики и проявляются в стертом, легком, среднем, тяжелом и осложненном вариантах, которые оцениваются по степени обезвоживания. В. И. Покровским было выделено несколько степеней обезвоживания, определяющим фактором которых является процент потерянной во время заболевания массы тела. К счастью, в 60% случаев холеры наблюдается развитие первой степени обезвоживания, которая быстро купируется пероральной регидратирующей терапией. Крайняя степень обезвоживания при холере наблюдается лишь в 10% случаев и является показанием для госпитализации пациента в реанимационное отделение.
Стертая клиническая форма холеры проявляется однократным жидким стулом, который не вызывает выраженного нарушения самочувствия пациента, а также не при каких условиях не проявляется обезвоживанием организма. Крайне редко, данная форма имеет острое начало и проявляется внезапным позывом на дефекацию и выделением водянистых фекалий, которые не вызывают болевых ощущений. Выделение стула происходит легко, а периодичность их учащается, кроме того, увеличивается и объем выделенных фекалий, которые имеют специфический характер по типу «рисового отвара», то есть не имеют выраженной окраски и запаха, полупрозрачную консистенцию. Кроме ускоренного акта дефекации, больной холерой в активном клиническом периоде отмечает появление урчания и неприятных ощущений в околопупочной области. Частота дефекации при легкой форме холеры составляет 3-5 раз за сутки, а средняя продолжительность клинических проявлений не превышает двух суток.
Среднетяжелая форма холеры проявляется прогрессированием клинических проявлений в виде неукротимой рвоты с выделением масс, подобные по внешнем виде с фекалиями. Рвота при холере не сопровождается тошнотой, однако, вызывает прогрессирование эксикоза, что проявляется мучительной жаждой, сухостью поверхности языка, бледность кожных покровов и слизистых оболочек, снижением тургора кожи и резким сокращением выделения мочи. Количество актов дефекации достигает десяти раз в сутки, причем каждый следующий акт сопровождается увеличением объема выделенных испражнений. Дополнительными симптомами эксикоза при кишечных инфекциях средней степени тяжести является повышенная судорожная готовность скелетной мускулатуры, не стойкий акроцианоз и осиплость голоса. Со временем у пациента появляются признаки умеренной тахикардии, гипотензии, олигурии, гипокалиемии, продолжительность которых в среднем составляет пять суток.
Тяжелая холера проявляется интенсивными симптомами эксикоза, обусловленного очень обильным стулом и многократной рвотой, во время которых выделяется до 15 л за один эпизод. Частым симптомом этой формы холеры становится появление болезненных судорог скелетной мускулатуры клонического и тонического характера. Голос при тяжелом эксикозе становится хриплым и слабым. Тургор кожи резко снижен, что проявляется длительным расправлением кожной складки, а кожа на кистях и стопах деформируется при наличии выраженных морщин. Лицо при холере принимает патогномоничные черты в виде запавших глаз, цианоза губ, ушных раковин.
Объективными пальпаторными признаками являются наличие усиленной урчание, переливание жидкости по кишечнику, шума плеска жидкости в брюшной полости, причем пальпация живота абсолютно безболезненна. Гепатоспленомегалия для холеры не характерна.
При длительном течении обезвоживание при тяжелой холере появляются дыхательные расстройства, нарастающая тахикардия , глухость сердечных тонов, артериальная гипотензия. Интоксикационные проявления в виде лихорадки не наблюдаются даже при тяжелом течении холеры.
Крайне тяжелая холера сопровождается молниеносным нарастанием клинических проявлений в виде массивной непрерывной дефекации и обильной рвоты, резкого прогрессирующего снижения температуры тела, дыхательных расстройств, анурии и гиповолемическим шоком. При отсутствии своевременной медикаментозной коррекции обезвоживании у больного холерой развиваются признаки пареза желудка и тонкого кишечника, что проявляется судорожной икотой и зияющим анусом, из которого свободно заканчивается «кишечная вода». Начало проведения регидратационной терапии сопровождается возникновением поноса и рвоты.
Крайне тяжелое течение холеры проявляется различной степенью нарушения сознания в виде сомнабуленции, сопора и даже комы, дыхательными расстройствами в виде появления патологического типа дыхания Биота. Объективными признаками холеры в этой ситуации является тотальный цианоз появление «темных очков » вокруг глаз», западение глазных яблок, отсутствие голоса. Кожные покровы становятся холодными и липкими на ощупь, пациент занимает в постели вынужденное положение по типу позы «борца», обусловленной развитием общего судорожного синдрома. Пальпация брюшной полости становится невозможной из-за выраженной болезненности, связанной с судорожными сокращениями прямых мышц живота.
Эпидемия холеры в стадии разгара чаще всего сопровождается развитием тяжелых клинических форм заболевания.
Наиболее тяжело протекает холера у детей раннего возраста, так как в них в короткие сроки возникают признаки вторичного поражения структур центральной нервной системы в виде адинамии, клонических судорог, конвульсии, нарушение сознания вплоть до комы. Трудности лечения детей, больных холерой, заключаются в определении первоначальной степени дегидратации. Клинические проявления холеры у детей отличаются многообразием и интенсивностью и проявляются в виде повышения температуры тела, склонности к развитию эпилептиформных припадков, обусловленные гипокалиемией. Средняя продолжительность активной клинической картины холеры у детей составляет десять суток, а прогнозы относительно выздоровления напрямую зависят от своевременности купирования эксикоза. В качестве распространенных причин развития летального исхода при холере выступают такие патологические состояния как гиповолемический шок и метаболический ацидоз .
Крайне тяжело протекает холера, что возникает у пациентов, страдающих тифопаратифозным заболеванием, так как в этой ситуации у человека развивается повышенный риск развития осложнений в виде кишечного кровотечения, перфорации измененной стенки подвздошной, слепой кишок, гнойного перитонита.
Диагностика холеры
Во время активного периода эпидемии холеры, а также при наличии у пациента патогномоничных клинических проявлений, верификация диагноза «холера» не составляет труда даже у врачей широкого профиля. В случае первичного установления холеры, диагноз обязательно должен подкрепляться данными бактериологического обследования. Выявление у человека клинических симптомов, схожих с холероподобным симптомокомплексом, является основанием для госпитализации и применения специфической лабораторной диагностики.
Основное лабораторное исследование холеры предусматривает применение бактериологического метода, который позволяет идентифицировать возбудителя. Серологическая лабораторная диагностика инфекционного заболевания может использоваться в качестве дополнительного обследования пациента, в результате длительного периода ее проведения.
В роли материала для проведения бактериологической диагностики холеры используются кишечное содержимое и рвотные массы пациента, в течение трех часов после забора должны быть доставлены в специализированную лабораторию. Как консерванты для сохранения биоматериала используется консервант в виде щелочной пептонной воды. Сбор биологического материала должен осуществляться в индивидуальные продезинфицированные судна. Испражнения в количестве 10 мл собираются в стерильные пробирки, которые плотно закрываются пробкой. Каждый образец должен быть промаркерован и содержать сопутствующую информацию о пациенте в виде имени и фамилии, названия образца, места и времени взятия.
В условиях специализированной лаборатории специалисты осуществляют засевания материала на питательные среды, а через 12-36 часов можно получить информацию о наличии или отсутствии роста специфической флоры. В качестве экспресс-методик при холере допускается применение таких лабораторных методов, как иммунофлуоресценция, иммобилизация, микроагглютинация, РНГА.
При первичном осмотре пациента, у которого имеются клинические признаки холеры, следует исключать другие инфекционные и неинфекционные патологии, сопровождающихся сходной симптоматикой, к которым относится гастроинтестинальная форма сальмонеллеза, острая дизентерия Зонне, острый неспецифический гастроэнтерит, стафилококковое пищевое отравление, ротавирусный гастроэнтерит.
Лечение холеры
Все терапевтические мероприятия применяются при холере должны быть направлены на восстановление объема циркулирующей крови и электролитной составляющей тканей, а также на ингибирование возбудителя.
Этиопатогенетическая терапия при холере должна начинаться с первых часов от дебюта клинических проявлений и заключается в проведении активной регидратации путем парентеральной инфузионной терапии с применением какого-либо изотонического полиионного раствора. Первичная регидратация предусматривает восполнение жидкости и солей, которые были потеряны до начала медикаментозной терапии, а корректирующее компенсаторная регидратация предусматривает коррекцию жидкостных и солевых потерь.
Медикаментозная регидратация рассматривается инфекционистами как реанимационное лечебное мероприятие, в котором особенно нуждаются пациенты, страдающие тяжелой формой течения холеры. В качестве полиионных растворов для инфузионной терапии следует отдавать предпочтение Трисоли, Квартасоли, Ацесоли, Хлосоли и Лактосоли, каждый из которых отличается содержанием в воде различного рода электролитов. Любой из данных полиионных растворов вводится внутривенно, после предварительного подогрева до 38°С. При различных степенях эксикоза при кишечных инфекциях может значительно варьировать рекомендуемая скорость введения раствора. Так, при второй степени обезвоживания раствор рекомендуется вводить со скоростью, которая не превышает 40-48 мл в минуту, а тяжелое течение заболевания является поводом для увеличения скорости введения препарата на несколько раз. Необходимый объем регидратации можно рассчитать путем определения исходных потерь жидкости.
Показателями эффективности применяемой инфузионной терапии является нормализация гемодинамических показателей, устранение дыхательных расстройств и восстановления голоса. При проведении регидратации следует учитывать, что длительное введение Трисоли может провоцировать развитие метаболического алкалоза и гиперкалиемии . С целью устранения электролитных нарушений больным холерой целесообразно назначать длительное применение Калия оротат по 1-2 таблетке трижды в сутки.
В ситуации, когда течение болезни сопровождается появлением пирогенной реакции в виде озноба, повышения температуры тела до полиионным растворам следует добавить 1% раствор Димедрола в объеме 1 мл, а при отсутствии положительного эффекта следует использовать однократное введение Преднизолона в суточной дозе 30 мг. наиболее распространенной ошибкой в лечении холеры является назначение коллоидных растворов в проведении регидратационной терапии, так как данные средства не восполняют потерю электролитов.
Для проведения регидратации детям, которые не достигли двухлетнего возраста, следует проводить капельную инфузию с введением 40% всего объема необходимой жидкости в первые шесть часов заболевания, а также пероральной регидратацией через назогастральный зонд. Показанием для прекращения водно-солевой терапии при холере является появление оформленных каловых масс, восстановление нормального диуреза и отсутствии рвоты.
Антибактериальная терапия при холере является второстепенной, однако, раннее применение антибиотиков позволяет сократить продолжительность активной клинической картины и ускорить очищение организма пациента от вибрионов. Препаратами выбора при холере является Тетрациклин в суточной дозе 15 г или Доксициклин в дозе 300 мг курсом пять суток. В педиатрической практике при холере применяется Триметоприм-сулъфометаксазол в расчетной суточной дозе 5 мг на кг массы тела, разделенной на два приема. В последнее время инфекционистами стал широко применяться Офлоксацин в лечении пациентов, страдающих холерой, эффективная доза которого составляет 400 мг в сутки продолжительностью пять суток.
Специальная диета в лечении холеры не используется, однако, в период реконвалесценции всем пациентам, перенесшим это заболевание, показано употребление продуктов питания, содержащих повышенную концентрацию солей калия (курага, томаты, картофель).
Профилактика холеры
Все профилактические меры, применяемые при холере должны выполняться в соответствии с официальными нормативными документами. Для организации эффективной противохолерной профилактики необходимо выделение помещений и соответствующей материально-технической базы, а также проведение специальной подготовки медиков. Санитарно-гигиенические профилактические мероприятия должны быть направлены на охрану источников питьевой воды, удаления и обеззараживания водных нечистот, осуществления санитарно-гигиенического контроля за водоснабжением населения.
В ситуации, когда создаются условия для распространения холеры, необходимо все усилия медицинских работников направить на выявление больных, страдающих острым желудочно-кишечным заболеванием с сопутствующим их госпитализацией и последующим однократным лабораторным обследованием на холеру. Все люди, прибывшие из эпидемически опасных очагов по холере должны подвергаться пятидневной обсервации и однократном лабораторного анализа испражнений на наличие возбудителя холеры.
Основными профилактическими противоэпидемическими мероприятиями по локализации очага холеры является применение ограничительных мероприятий и карантина, выявления и изоляции лиц, контактирующих с больными и вибриононосителями, лечение пациентов в полном объеме, текущей и заключительной дезинфекции.
Все лица, перенесшие холеру или в которых установлено вибриононосительство, подлежат диспансерному наблюдению, а профилактические меры в отношении населения в очаге должны применяться в течение года после вспышки холеры.
Специфическая профилактика холеры осуществляется методом использования холерной вакцины и холероген-анатоксина, который применяется исключительно по эпидемическим показаниям. Холерная вакцина содержит 8-10 вибрионов и вводится подкожно в объеме 1 мл, а повторное введение осуществляется через десять суток в объеме 15 мл Дозами противохолерной вакцины, которая применяется в педиатрии, является 07 мл и 1 мл Холероген-анатоксин необходимо применять в эпидемических очагах ежегодно. Ревакцинация проводится исключительно при наличии эпидемических показаний через три месяца после первичной вакцинации методом подкожного введения в дозе 05 мл для взрослых и 01 мл для детей.
Холера – какой врач поможет ? При наличии или подозрении на развитие болезни следует немедленно обратиться за консультацией к таким врачам как терапевт, инфекционист.
diagnoz.info
Холера. Возбудитель заболевания — холерный вибрион. Симптомы, лечение и профилактика. Фото
Холера. Возбудитель заболевания — холерный вибрион. Симптомы, лечение и профилактика. ФотоСтатьи раздела «Особо опасные инфекции»
В Российской Федерации холера вместе с чумой, туляремией, желтой лихорадкой, сибирской язвой и натуральной оспой входит в перечень особо опасных инфекций. Эти заболевания относятся к карантинным инфекциям. На них распространяются международные санитарные соглашения, которые включают в себя перечень мероприятий по организации строгого государственного карантина, ограничивающего передвижения больных.

Рис. 1. Знак биологической безопасности.
В 1853 году Ф. Пачини и Э. Недзвецкий открыли возбудитель холеры – холерный вибрион, а в 1883 году Р. Кох выделил культуру возбудителя и подробно его изучил.
С 1817 года на планете Земля было зарегистрировано 7 пандемий заболевания. Наиболее распространена холера в Индии, которая является колыбелью заболевания.
Распространяет инфекцию только больной человек. С рвотными массами и испражнениями в окружающую среду попадает огромное количество возбудителей, которые в последующем с водой, предметами обихода больного и пищевыми продукты попадают в организм огромного количества людей, вызывая эпидемию.
Начало заболевания всегда острое и внезапное. Основные симптомы холеры связаны с обезвоживанием, которое приводит к потере жидкости и минералов. Гиповолемический шок и острая почечная недостаточность становится причиной смерти больного. Профилактика холеры, адекватное лечение и гигиена являются основой предупреждения развития заболевания.

Рис. 2. Роберт Кох в 1883 году выделил культуру и подробно изучил холерный вибрион.

Рис. 3. Река Ганг. Среди большого скопления людей холера распространяется молниеносно.
Характеристика возбудителя холеры
Учеными открыто около 150 серогрупп холерного вибриона. Возбудитель холеры холерный вибрион (Vibrio cholerae 01) входит в серогруппу 01. Существует 2 биотипа вибрионов серогруппы 01, отличающихся друг от друга по биохимическим характеристикам: классический (Vibrio cholerae biovar cholerae) и Эль-Тор (Vibrio cholerae biovar eltor). Возбудитель холеры — это грамм отрицательная палочкообразная бактерия, слегка изогнутая, имеющая длинный жгутик.
- В открытых водоемах холерный вибрион Эль-Тор сохраняет жизнеспособность несколько месяцев. Более 1-х суток живет в сточных водах. Хорошо развивается в мясных продуктах и молоке.
- Губительными для бактерии являются кипячение, дезинфицирующие средства, солнечные лучи и антибиотики группы фторхинолов и тетрациклина.
- Экзотоксин (холероген) вибриона представляет собой термостабильный белок, молекула которого состоит из 2-х компонентов. Токсин возбудителя способен реализовать свое действие только на клетках кишечника. Компонент Б готовит клетку кишечного эпителия для проникновения компонента А, субъединица которого (А1) обуславливает развитие дегидратации (обезвоживания) и потерю минералов больным путем активизации выхода жидкости и электролитов из клеток либеркюновых желез.

Рис. 4. На фото возбудитель холеры — холерный вибрион (электронная микроскопия).

Рис. 5. На фото возбудитель холеры — холерный вибрион. Увеличение в 13 000 раз.
к содержанию ↑Как развивается заболевание
Возбудители холеры попадают в желудочно-кишечный тракт, где, не выдерживая его кислого содержимого, массово гибнут. Если желудочная секреция снижена и рН >5,5, вибрионы быстро проникают в тонкий кишечник и прикрепляются к клеткам слизистой оболочки, при этом не вызывая воспаления. При гибели бактерий, выделяется экзотоксин, приводящий к гиперсекреции клетками слизистой оболочки кишечника солей и воды. Действие экзотоксина холерагона усиливается при участии других токсических компонентов вибриона – ферментов, низкомолекулярных метаболитов и простаноидов.
к содержанию ↑Эпидемиология заболевания
- Носители холерного вибриона и больные холерой являются резервуаром и источником инфекции.
- Самыми опасными для заражения являются первые дни заболевания. Опасность инфицирования окружающих исчезает к 3-й неделе заболевания. Отмечаются случаи, когда человек является носителем возбудителя в течение года. Из-за трудностей выявления больных, страдающих легкими формами заболевания, эта категория больных представляет самую большую опасность.
- Наиболее распространена в настоящее время холера, вызванная возбудителем серогруппы 01 Vibrio cholerae biovar eltor (холера Эль-Тор). Она характеризуется большим количеством носителей заболевания и больных со стертыми формами.
- Наибольшее количество случаев заболевания регистрируется в теплое время года. В местах локализации эндемических очагов заболевания часто заболевают дети до 5-и лет.
- Транспортные средства, международный туризм, реки, возросшая миграция, авиашоптуры и переселенцы являются путями миграции возбудителя.
Пути передачи холеры
Вода – основной путь передачи инфекции. Инфекция так же распространяется с грязными руками через предметы быта больного и пищевые продукты. Переносчиками инфекции могут стать мухи.
Вибрионы холеры размножаются в организмах ракообразных, моллюсков и рыб. Недостаточно термически обработанные морепродукты становятся источником заболевания. Пониженная кислотность желудка способствует развитию заболевания.

Рис. 6. Вода – основной путь передачи инфекции.

Рис. 7. Азовские креветки заразились холерой.

Рис. 8. Устрицы и другие моллюски, инфицированные холерным вибрионом, являются одной из главных причин распространения заболевания в США.
к содержанию ↑Симптомы холеры
Симптомы холеры имеют свою специфичность и течение.
- Начало заболевания холерой всегда всегда острое и внезапное. Инкубационный период составляет от нескольких часов до 5-и суток.
- Позывы к дефекации возникают сразу после инкубационного периода и всегда безболезненны. Вначале выделения с каловыми массами, а потом водянистые. Их частота увеличивается и достигает до 10 раз в сутки. Отличительной особенностью заболевания является отсутствие зловонного запаха. В связи с постоянным выходом жидкости в просвет кишечника объем каловых масс не уменьшается, а порой и увеличивается. В 1/3 случаев испражнения напоминают «рисовый отвар». Постоянное урчание в животе.
- Боли в животе регистрируются у третей части больных.
- Прогрессирующая общая слабость.
- Больного мучает постоянная жажда и сухость во рту.
- Температура тела постепенно падает. Больной постоянно мерзнет.
- Резко падает артериальное давление, что проявляется чувством оглушенности и звоном в ушах.
- Через несколько суток появляется рвота, которая постоянно усиливается. Тошнота отсутствует.
- Далее начинают появляться судороги. Болезнь развивается при полном сохранении сознания.
- Кожа бледнеет, становится холодной на ощупь, ее тургор снижается. Развивается акроцианоз, который со временем приобретает тотальный характер. Вокруг глаз кожа темнеет, что напоминает «очки». Кожа на пальцах рук сморщивается и напоминает «руки прачки».
- Слизистые оболочки глаз теряют блеск, голос становится глухим и со временем пропадает вовсе. Черты лица заостряются и западают глаза. Втягивается живот.
- Падает артериальное давление. Тахикардия прогрессирует.
- Количество выделяемой мочи резко уменьшается.
Признаки и симптомы резкого обезвоживания организма
При потере организмом больного до 9 — 10% жидкости в расчете от общей массы тела говорят о крайней степени обезвоживания. При этом:
- Периферическое артериальное давление не определяется.
- Учащается рвота и позывы на рвоту, понос прекращается из-за развития пареза кишечника.
- Резко снижается температура тела.
- Одышка усиливается.
- Моча прекращает выделяться.
Потеря большого количества жидкости приводит к потере организмом солей, сгущению крови, нарушению микроциркуляции, кислородному голоданию тканей и развитию метаболического ацидоза. Развивается недостаточность работы почек и всех внутренних органов. Смерть больного наступает от дегидратационного шока.

Рис. 9. Крайняя степень обезвоживания.

Рис. 10. Крайняя степень обезвоживания. Живот втянут. Кожная складка на животе не расправляется.
к содержанию ↑Осложнения холеры
- В случае присоединения вторичной инфекции развиваются пневмонии, абсцессы и флегмоны.
- В результате проведения длительных внутривенных манипуляций развиваются флебиты и тромбофлебиты.
- Нарушение реологических свойств крови становится причиной инсультов, развития тромбоза сосудов кишечника и сердечной мышцы.
Лабораторная диагностика холеры
Результат простой микроскопии испражнений помогает установить предварительный диагноз уже в первые часы заболевания.
Методика посева биологического материала на питательные среды является классическим методом определения возбудителя холеры. Результаты получаются через 36 – 48 часов. Для его проведения используются рвотные массы и испражнения больных, загрязненное белье и секционный материал.
Ускоренные методики диагностики холеры подтверждают результаты основного метода диагностики, но не являются достоверными источниками, доказывающими наличие заболевания.

Рис. 11. Микробиологическая диагностика холеры проводится в режимных лабораториях.

Рис. 12. На фото холерный вибрион Эль-Тор при увеличении в 208 раз.
Рис. 13. На фото культура возбудителя.
к содержанию ↑Лечение холеры
Лечение холеры направлено на:
- восполнение потерянной в результате заболевания жидкости и минералов,
- борьбу с возбудителем.
Лечение холеры на первом этапе
На первом этапе лечения заболевания восполняется потеря жидкости и солей больным. Количество вводимых растворов должна соответствовать дефициту исходной массы тела.
Лечение холеры на втором этапе
На втором этапе лечения продолжается восполнение регидрантов в объеме, теряющим больным в течение заболевания. Восполнять потерянную жидкость можно оральным и парентеральным путями. При потере жидкости от 6 до 10% показано внутривенное струйное введение растворов.
Борьба с холерным вибрионом
Возбудитель холеры чувствителен к антибактериальным препаратам группы тетрациклина, фторхинолов и макролидов. Хорошо зарекомендовали себя такие антибиотики, как доксициклин, ципрофлоксацин и эритромицин.
Адекватное лечение холеры и хороший иммунитет способны остановить прогрессирование заболевания на любом из этапов его развития.

Рис. 14. Оказание помощи больному с холерой.

Рис. 15. Одно из первых лечебных мероприятий – организация внутривенного введения растворов для восполнения потерянной в результате заболевания жидкости и минералов.

Рис. 16. Лечение холеры направлено на восполнение потери жидкости у ребенка через рот.
к содержанию ↑Иммунитет при холере
Иммунитет у лиц после заболевания характеризуется как длительный и напряженный. У лиц, ранее перенесших заболевание, практически не выявляются случаи рецидива.
Защита организма от инфекции происходит двумя путями:
- При заболевании из крови в просвет кишечника проникают антитела (антибактериальные иммуноглобулины SIgA), которые препятствуют слипанию вибрионов холеры с клетками слизистой оболочки кишечника.
- При заболевании клетки кишечника начинают продуцировать собственные антитела, обладающие токсическим действием в отношении возбудителей холеры.
к содержанию ↑Совместное действие антибактериальных и антитоксических антител в кишечнике создает более благоприятные условия для уничтожения и выведение возбудителя.
Прогноз заболевания
Своевременно начатое лечение холеры быстро возвращает больного в строй. Уже через месяц трудоспособность больного восстанавливается. Высокая смертность отмечается при отсутствии адекватного лечения.
к содержанию ↑Эпидемический надзор
Мероприятия по эпидемическому надзору за заболеванием основаны на предупреждении заноса и распространения инфекции и включают в себя:
- отслеживание уровня заболеваемости и возникновения новых случаев холеры в других странах мира;
- проведение постоянного лабораторного контроля за безопасностью открытых водоемов;
- выполнение мероприятий, направленных на уничтожение возбудителя при обнаружении вирулентных штаммов.

Рис. 17. Команда медицинских работников готова к работе в очаге особо опасной инфекции.
к содержанию ↑Профилактика холеры
Мероприятия по профилактике заболевания холерой включают в себя:
- выполнение в полном объёме мер, направленных на предупреждение заноса инфекции из-за рубежа, регламентированных специальными документами;
- меры по предупреждению распространения холеры из природных очагов;
- улучшение социально-экономических и санитарно-гигиенических условий жизни населения;
- санитарно-гигиенические мероприятия включают в себя организацию обеззараживания воды и мест общего пользования. Мытье рук и достаточная термическая обработка пищи помогут избежать заболевания.
- своевременное выявление и адекватное лечение больных и носителей инфекции;
- вакцинирование населения по эпидемиологическим показаниям.

Рис. 18. Санитарно-гигиеническая бригада в костюмах защитных.

Рис. 19. Действия эпидемиологов при отборе проб воды.

Рис. 20. Мытье рук, овощей и фруктов поможет избежать заболевания.
к содержанию ↑Эпидемии холеры в настоящее время
По данным Всемирной организации здравоохранения в год заболевает холерой от 3 – 5 млн. человек, из них 100 тыс. человек умирает. Заболевание распространено в 40 – 50 странах мира. Чем ниже уровень жизни людей в стране, тем чаще там возникают эпидемии инфекционных заболеваний, в том числе холерой. Являясь высоко заразной, холера убивает более 1,5 млн. детей в год. По данным ВОЗ более 2,5 млрд. человек на Земле не пользуются туалетом, не имеют возможности мыть руки. Более 1 млрд. человек испражняются на открытом воздухе рядом со своим жилищем. Множество мух являются переносчиками всевозможных инфекций.
Самые распространенные вспышки холеры встречаются в Африке, Азии и Индии. На Камерун, Гану, Нигерию, Конго и Чад приходится большинство случаев со смертельным исходом. Во многих африканских странах население даже не знает, что такое больница. А ведь даже в самых развитых странах мира при возникновении холеры госпитализируется более 50% заболевших.

Рис. 21. Отсутствие питьевой воды – один из факторов развития кишечных эпидемий.

Рис. 22. Полное отсутствие санитарных норм – один из факторов развития эпидемий.

Рис. 23. На фото холера у ребенка. Отсутствие чистой воды – важнейшая причина смертности детей.

Рис. 24. Отсутствие чистой воды – важнейшая причина смертности детей от холеры.

Рис. 25. Вода из реки Конго обеспечивает население водой для питья и приготовления пищи. В ней стирают. В нее спускается канализация.

Рис. 26. Трущобы Фритаун в Кроо Вау. Мать моет своего ребенка.

Рис. 27. Отсутствие санитарных норм, бедность и нищета – причины заболевания.

Рис. 28. Отсутствие питьевой воды – один из факторов развития кишечных эпидемий.

Рис. 29. Эпидемия заболевания в Эфиопии.

Рис. 30. 8 тыс. человек умерло от эпидемии холеры на Гаити в 2010 году.

Рис. 31. Эпидемия в Нигерии. Полное отсутствие санитарных норм.

Рис. 32. Эпидемия заболевания в Гоме (Африка). На фото жертва холеры – маленький ребенок.

Рис. 33. 2015 год. Эпидемия холеры в Зимбабве может превысить 60000 случаев.

Рис. 34. 2015 год. Наводнение в Пакистане. 1,5 тыс. человек уже погибло. Смерть наступает от голода и отсутствия питьевой воды.

Рис. 35. Эпидемия в Южном Судане. Женщина принимает вакцину против холеры.

Рис. 36. Пероральная вакцина против холеры помогает спасти человеческие жизни.
Холера уносила миллионы жизней в прошлом. Сегодня заболевание распространено в 50 странах мира. Отсутствие питьевой воды, санитарных норм, бедность и нищета – причины заболевания. Распространяет инфекцию больной человек. Возбудитель холеры (холерный вибрион) быстро размножается в открытых водоемах, куда стекает канализация. Симптомы холеры связаны с поражением желудочно-кишечного тракта. Понос и рвота приводят к быстрому обезвоживанию организма. Профилактика холеры состоит из целого ряда медико-санитарных и ветеринарных мероприятий. Улучшение социально-экономических и санитарно-гигиенических условий жизни населения препятствуют распространению заболевания.

Рис. 37. На фото холерный вибрион.
ССЫЛКИ ПО ТЕМЕСтатьи раздела «Особо опасные инфекции»Самое популярноеПОНРАВИЛАСЬ СТАТЬЯ?
Подпишитесь на нашу рассылку!
Статьи раздела «Особо опасные инфекции» Новые статьи Популярные статьи Похожие статьи О микробах и болезнях © 2019 Наверхmicrobak.ru
10.1.6. Возбудитель холеры
Холера – особо опасная, карантинная инфекционная болезнь, вызываемая некоторыми представителями вида Vibrio cholerae, характеризующаяся поражением тонкой кишки, нарушением водно-солевого обмена и интоксикацией. Холерный вибрион был выделен в 1883 г. Р. Кохом от больного холерой. В 1906 г. на карантинной станции Эль-Тор в Египте при обследовании паломников Ф. и У. Готшлихи выделили вибрион Эль-Тор.
Таксономия. Холерный вибрион относится к отделу Gracilicutes-, семейству Vibrionaceae, роду Vibrio. Внутри вида Vibrio cholerae различают 2 основных биовара: biovar cholerae classic (выделенный Р. Кохом) и biovar eltor (открытый Ф. и Е. Готшлихами).
Морфология и тинкториальные свойства. Холерный вибрион – небольшая грамотрицательная изогнутая палочка длиной 2-4 мкм, толщиной 0,5 мкм, не образует спор, не имеет капсулы, монотрих и чрезвычайно подвижен.
Культивирование. V. cholerae – факультативный анаэроб, но предпочитающий аэробные условия, поэтому на поверхности жидкой питательной среды образует пленку. Оптимальная температура для роста 37ºС, наиболее благоприятное значение рН среды в отличие от других микроорганизмов равно 8,5-9,0. Холерный вибрион – очень неприхотливый микроорганизм: растет на простых питательных средах, таких как 1 % щелочная лептонная вода, щелочной агар. Эти среды являются элективными для него. Характерной особенностью V. cholerae является быстрый рост – пленка на поверхности жидкой среды образуется через 6-8 ч. На плотной среде образует мелкие голубоватые колонии.
Ферментативная активность. Биохимическая активность холерного вибриона достаточно высока; он обладает большим набором ферментов. При идентификации наиболее важным является определение его отношения к маннозе, арабинозе и сахарозе. По способности ферментировать эти углеводы Хейберг все вибрионы семейства Vibrionaceae разделил на 8 групп; холерный вибрион относится к 1-й группе (манноза+, арабиноза-, сахароза+).
Антигенная структура. Холерный вибрион имеет О- и Н-анти-гены; в зависимости от строения О-антигена у него различают более 150 серогрупп. Возбудитель холеры относится к серогруппам О1 и О139 (его обозначение V. cholerae O1 и V. cholerae 0139), все другие представители вида V. cholerae не являются возбудителями холеры, но могут вызывать, например, гастроэнтериты. О-антиген состоит из 3 компонентов: А, В и С. В зависимости от их сочетания различают 3 серовара возбудителя холеры – Огава (АВ), Инаба (АС) и Гикошима (ABC). Н-анти-ген неспецифичен для V. cholerae, он является общим для всего рода Vibrio.
Факторы патогенности. Холерный вибрион образует эндотоксин. Кроме того, он выделяет экзотоксин, состоящий из нескольких фракций, наиболее важной из которых является холероген. Холероген вызывает гиперсекрецию воды и хлоридов в просвет кишечника, нарушение обратного всасывания натрия, в результате возникает диарея, приводящая к обезвоживанию организма. Экзотоксин обладает также цитотоксическим действием и вызывает гибель клеток эпителия тонкой кишки. У возбудителя холеры имеются ферменты агрессии – фибринолизин, гиалуро-нидаза, лецитиназа, нейраминидаза. Патогенность связана также с адгезивными свойствами (белки наружной мембраны), подвижностью вибриона. Дифференциация биоваров clolerae и eltor, сходных по всем перечисленным свойствам, производится с помощью ряда тестов; наиболее важные из них – чувствительность к специфическим бактериофагам, полимиксину и агглютинации куриных эритроцитов.
Резистентность. Более устойчивым к нагреванию, действию солнечных лучей, дезинфицирующим средствам является биовар eltor, хотя его резистентность сравнительно невысока. Очень чувствителен холерный вибрион к кислотам.
Восприимчивость животных. Животные к возбудителю холеры нечувствительны.
Эпидемиология. Холера – заболевание, известное с древних времен, но до начала XIX в. она встречалась только в Индии, где существовал постоянный очаг инфекции, сохраняющийся и в настоящее время. В 1817 г. очередная эпидемия холеры в Индии впервые вышла за ее пределы и охватила многие страны. В 1817-1926 гг. было 6 пандемий холеры; с 1961 г. началась седьмая пандемия, причиной которой явился биовар eltor. В настоящее время регистрируется восьмая пандемия, вызванная V. cholerae 0139 biovar eltor. Холера встречается более чем в 90 странах всех континентов, кроме Антарктиды. Это антропоноз-ная инфекция; источником инфекции являются больные люди и носители (носительство биовара eltor встречается значительно чаще, чем биовара clolerae). Механизм передачи инфекций – фекально-оральный, среди путей передачи преобладает водный, однако возможны пищевой и контактно-бытовой.
Патогенез. Вибрионы, попадающие через рот в желудок, в результате действия соляной кислоты могут погибнуть. Однако при поступлении большого количества возбудителей и снижении кислотности желудочного содержимого (разбавление его водой, пищей, гастрит со сниженной кислотностью) вибрионы попадают в тонкую кишку, размножаются, прикрепляясь к ее эпителию, и выделяют экзотоксин, который нарушает водно-солевой обмен, приводит к резкому обезвоживанию организма и ацидозу. Испражнения, состоящие из жидкости и погибших клеток слизистой оболочки, имеют вид рисового отвара. При гибели вибрионов освобождается эндотоксин, вызывающий интоксикацию.
Клиническая картина. Инкубационный период продолжается от 1 до 6 дней. Заболевание развивается остро – с повышения температуры тела, рвоты, поноса (испражнения и рвотные массы имеют вид рисового отвара). Эта стадия продолжается 1-3 дня, затем заболевание может или закончиться (при легкой форме холеры) или перейти в следующую стадию – стадию гастроэнтерита (форма средней тяжести), когда усиливаются рвота и понос, больной теряет до 30 л жидкости в сутки. Резкое обезвоживание приводит к нарушениям сердечно-сосудистой, дыхательной систем, судорогам. Затем заболевание может перейти в третью стадию (тяжелая форма холеры) – холерного алгида (от лат. algidus – холодный), характерным признаком которого является снижение температуры тела до 34ºС. Холерный алгид заканчивается смертью больного. Биовар eltor в отличие от биовара cholerae чаще вызывает заболевание, протекающее в легкой форме.
Иммунитет, вероятно, непрочный и непродолжительный.
Микробиологическая диагностика. Материалом для исследования являются рвотные массы, испражнения, пищевые продукты, вода. Как ориентировочный может быть использован бактериоскопический метод. В основном применяют бактериологический метод, позволяющий идентифицировать возбудителя (определить V. cholerae O1 или 0139), установить чувствительность к антибиотикам, провести внутривидовую идентификацию – выявление биовара и серовара. Экспресс-диагностику холеры производят с помощью РИФ.
Лечение. Назначают антибиотики широкого спектра действия и вводят плазмозамещающие жидкости.
Профилактика. Главные профилактические мероприятия – неспецифические санитарно-гигиенические и карантинные. Для специфической профилактики, имеющей вспомогательное значение, применяют холерную убитую вакцину и холерную комбинированную вакцину, состоящую из двух компонентов: холерогена-анатоксина и О-антигена холерного вибриона.
studfiles.net